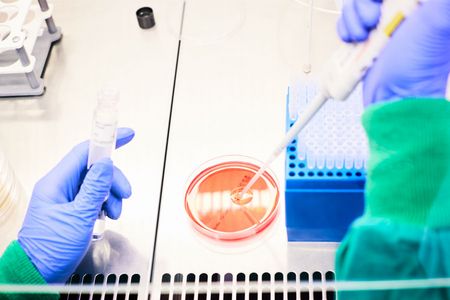

Wer wir sind
Das Marienhospital ist zweitgrößter Arbeitgeber im Süden von Stuttgart. Wie in keinem anderen Krankenhaus verbinden sich bei uns Tradition mit Moderne. Im Mittelpunkt der täglichen Arbeit stehen Spitzenmedizin und qualitativ hochwertige, zugewandte Pflege gegenüber unseren Patienten. „Nähe zu den Menschen und Offenheit für alles, was sie bewegt“ prägt unser Haus seit 1890 bis heute. „MEDIZIN LEBEN. MENSCH SEIN.“ ist die Botschaft unseres Hauses an alle, die sich vertrauensvoll an uns wenden.
Folgende „Benefits“ erwarten Sie während Ihrer Ausbildung:
Dienstkleidung
Ihre Berufskleidung stellen wir Ihnen kostenlos zur Verfügung. Für das Waschen sorgen wir ebenfalls.
Wohnen und Wohlfühlen
Für den praktischen Teil Ihrer Ausbildung stehen Ihnen in unserem hauseigenen Wohnheim günstige Zimmer zur Verfügung. Die Wohnanlage befindet sich direkt hinter dem Marienhospital, ist zentrumsnah, aber trotzdem ruhig. Sie liegt im beliebten Stuttgarter Süden – einem Stadtteil, der mit Cafés, Bars, Kino, Theater und Einkaufsmöglichkeiten viel Raum für Freizeitaktivität bietet. Zu Fuß erreichen Sie in 15 Minuten die Stuttgarter Innenstadt, mit öffentlichen Verkehrsmitteln sind Sie nach fünf Minuten Fahrt dort.
Kulinarisch bestens versorgt
Sie können in der Mitarbeitercafeteria täglich zu günstigen Preisen frühstücken und zu Mittag essen.
Ihre Freizeitmöglichkeiten
In den nahegelegenen Weinbergen können Sie Abstand vom Arbeitsalltag und dem Stadttrubel finden. Einen weiteren Ausgleich bieten Ihnen verschiedenen Betriebssport-Möglichkeiten, zum Beispiel unser Volleyballtraining. Außerdem bekommen Sie ein vergünstigtes Nahverkehrsticket. Weitere Informationen finden Sie hier.
Ausbildungsbegleitung / besondere Angebote
Eine gute Betreuung während der Ausbildung ist uns sehr wichtig: Wöchentlich stehen Sie im intensiven Austausch mit der Ausbildungsverantwortlichen und mit anderen Auszubildenden des gleichen Fachs. Darüber hinaus bieten wir Auszubildendentage an, an denen Sie Auszubildende anderer Fachrichtungen kennenlernen. Bei Fragen oder Problemen können Sie sich an unsere Ausbildungskoordinatorin oder unsere Konfliktnavigatoren wenden.